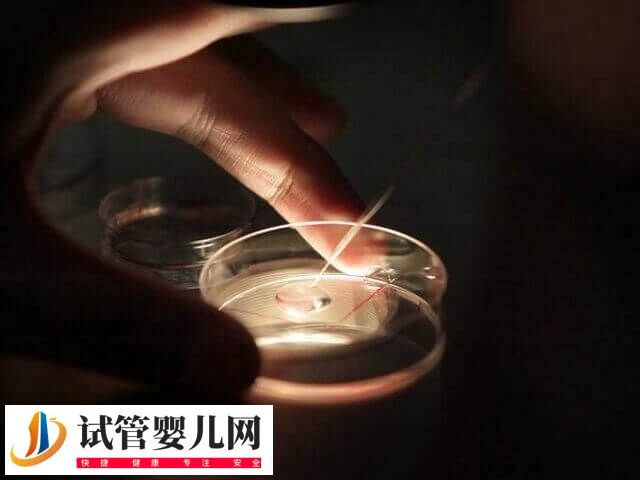
5个受精卵养囊成功2个怎么回事(图2) 5个受精卵养囊成功2个怎么回事(图2)

在促排卵的第15天,卵泡的正常大小通常应该达到15-18m左右。不过因每位女性的生理状况可能有所不同,因此卵泡的实际大小可能会有所差异。有的促排卵泡可能会长到22-25毫米,具体因人而异。此外,如果在进行促排卵治疗15天后卵泡仍然未能长大,那么建议患者要及时就医处理。

5个受精卵养囊成功2个说明什么
在胚胎体外培养过程中,前3天的胚胎为卵裂期胚胎,也是正常受精的胚胎,如果患者需要继续培育胚胎,那么可以进行养囊,即胚胎体外培养5-7天时,就会形成囊胚,而这也是胚胎体外培养的终末阶段,至于5个受精卵养囊成功2个代表什么意思,可参考下列内容:
1、受精卵质量好
5个受精卵养囊成功2个,通常代表受精卵胚胎质量好,也就是说患者具备健康优质的精子和卵子,一般只有优质的精卵,才能在结合只收,有较好的发育潜能,进而成为囊胚。
2、实验室设施设备好
患者的5个受精卵养囊成功2个,通常也离不开胚胎实验室环境,如果医院实验室设施设备好,那么保障养囊顺畅,进而能提高囊胚培养的几率,成功培育多个囊胚。
3、医生技术不错
养囊的关键除了实验室设施设备好、受精卵质量好外,还会受到医生养囊技术的影响,一般5个受精卵养囊成功2个,那么说明医生养囊技术还是不错的。
5个受精卵养囊成功2个是非常不错的,毕竟囊胚培养的过程也是优胜劣汰的过程,只有各个养囊关键步骤正确,才能使受精卵胚胎有较大机率培养为囊胚。
五个受精卵可以养几个囊胚
一般来说,并不是所有的卵裂期胚胎均可培养为囊胚,这是因为囊胚培养要求较高,只有筛选出具有更高发育潜能的胚胎,才能进一步发育成囊胚,进而提高移植入母体后妊娠的成功率。具体如下:
- 通常患者如果拥有五个受精卵胚胎,根据囊胚培养成功几率,大概可以养2-3个囊胚;
- 如果患者的精卵质量比较好,那么也可能成功养囊4个,但具体还要以实际为准,不可一概而论。






